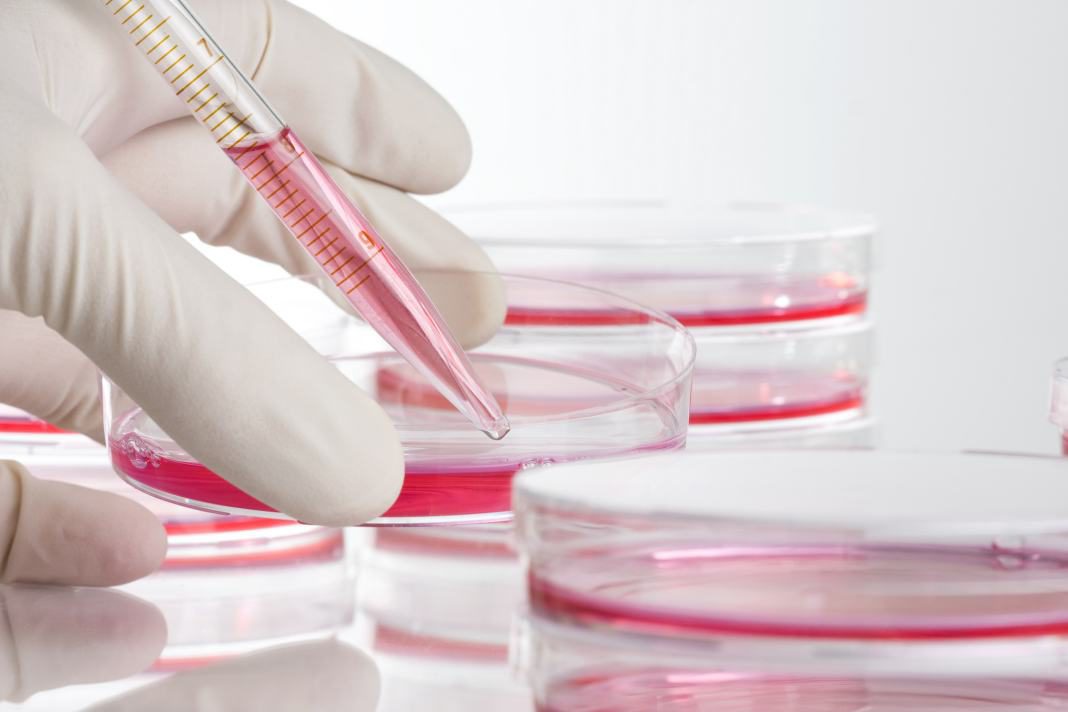

Bjorn Thomas, MBBS1,2 and Jerry K. L. Tan, MD, FRCPC3,4,5
1 Skin Tumor Unit, St. John’s Institute of Dermatology, London, UK
2 Division of Genetic & Molecular Medicine, King’s College School of Medicine, London, UK
3 Department of Medicine, University of Western Ontario, London, ON, Canada
4 Windsor Clinical Research Inc, Windsor, ON, Canada
5 Windsor Regional Hospital, Windsor, ON, Canada
Introduction
Acne is a common dermatological condition found in about 85% of adolescents and young adults.1 Acne can have significant psychological, social or physical impacts. Many effective treatments are available to manage acne, but for best results, all therapeutic interventions require good patient adherence. Unfortunately, for a variety of reasons, the risk of poor adherence has been documented in around 50% of acne patients.2
Acne Overview
Acne is a chronic inflammatory skin disease characterized by four pathological processes, with treatments targeted at the various mechanisms felt to be responsible for its development:
- Sebaceous hyper secretion – oral isotretinoin, antiandrogen oral contraceptives
- Abnormal keratinization of the walls of the pilosebaceous unit – topical retinoids
- Proliferation of Propionibacterum acnes – benzoyl peroxide, antibiotics
- Inflammation – antibiotics, retinoids2
Measuring Acne Severity
- Severity of acne can be described objectively by the physician and subjectively by the patient.
- Mild acne is characterized by open and closed comedones (black and whiteheads, respectively) and few papulopustular lesions.
- Moderate acne includes papules, pustules, and no more than one nodule.
- Severe acne is widespread and includes all the lesions above. Even the presence of a few cysts or nodules can be indicative of severe acne.
- Acne on the trunk is more difficult to treat, thereby increasing the severity rating even if the lesion counts are modest.
- Scarring is very common and should be taken as an indication for aggressive therapy.Scarring may be produced even in mild acne.
- The objective severity of acne typically drives particular treatment rationales; although, the physician should include patient values and preferences to help guide therapeutic strategies.
- Furthermore, acne of any grade can be considered more severe if there is significant psychological upset.
Treatment Rationale
Acne treatment information usually starts at the patient’s local pharmacy or, increasingly, online. Skin cleansers, skin wipes, and lifestyle changes, which will be discussed below, are usually the first considerations for patients with acne. Typically, when the patient feels their acne is not improving or when it has breached the patient’s disease ‘threshold’ by becoming ‘too severe’, they might consult their family doctor or dermatologist. Many treatment options (Table 1) are available that target one or more of the pathological processes
described above. However, because of its multifactorial
pathogenesis, combination therapy is frequently prescribed.
The purpose of treatment is to improve the quality of life
for patients and to prevent long-term sequelae, particularly
scarring and psychological distress.
| Acne Severity | Therapy |
| Mild acne |
|
| Moderate acne |
|
| Severe acne |
|
Table 1: Overview of treatment options for acne | |
Optimizing Treatment Adherence
- In acne, as in many other disorders, adherence to treatment is essential for successful therapeutic results as well as improving outcomes.2
- The reasons attributable to the high rate of poor adherence can be categorized into patient factors, physician factors, treatment-related issues, and disease characteristics.
- Unfortunately, acne has a few unavoidable characteristics that can be difficult for patients to accept:2
- Clinical improvement is usually seen 6-8 weeks after treatment is started.
- There may be an initial flare-up of inflammation.
- Relapses are frequent and cures are not, causing treatment fatigue that may contribute to adherence difficulties.
- Many factors have an effect on adherence in acne treatment (Table 2).
| Negative Effect on Adherence | Positive Effect on Adherence |
|
|
Table 2: Factors associated with effects on adherence to acne treatment2 | |
In order to optimize adherence to treatment, the physician
first needs to quantify and measure compliance to therapy.
Many methods are available to assess adherence, although one quick, effective, and validated tool that can be used in
a clinical setting is called the ECOB (Elaboration d’un outil d’evaluation de l’observance des traitements medicamenteux)
questionnaire (Table 3). In this mini-questionnaire, adherence
is considered poor if at least one answer given is different from
the answers expected. If a physician suspects poor adherence,
it is important to gently investigate the reasons as to why
adherence is suboptimal.
| Oral Treatment | Topical Treatment |
|
|
| *Colour of packaging was acceptable as a correct answer. If at least one answer is different from the expected answers (written in blue above), the patient’s adherence is considered to be poor. The ‘adherence scale’ based on this selection can be considered as an aid to measure the risk of poor adherence, but it does not allow an exact determination. | |
Table 3: ECOB questionnaire to assess the risk of poor adherence2 | |
Tips to Improve Adherence 3
- An open empathetic approach can help establish trust
- Dedicated appointments for acne counseling – either nurse or doctor led
- Patient education about etiology, prevalence, and myths associated with acne
- Provide written information (i.e., handouts/leaflets) or online resources on acne, and also on their specific treatments, including expectations
- Address nonadherence promptly
- If current treatment is unsatisfactory, be willing to modify
- Recommend simplified treatment and skin care regimes, including an appropriate moisturizer and mild, gentle cleanser, to suit the patients needs2
Non-drug Interventions and Recommendations
Dispel common acne myths:
- Acne is due to being dirty
- Hourly washing does not make a difference
- Acne is due to ‘hormonal imbalance’
- Hormonal levels are normal in the majority of acne patients
- Acne is related to sexual behaviour
There is no proven association with the level of sexual activity4
Topical treatment considerations that can encourage adherence:
- Using medication on sites that are easily accessible (face and upper trunk)
- Keeping the regimen simple and quick to use
- Selecting therapies with cosmetic acceptability
- Minimizing factors that produce irritation of the skin; many anti-acne topicals are irritating
- Applying the topicals on the entire acne-prone area to prevent new acne lesions is fundamental, rather than on existing acne lesions only
- Using short contact application (e.g., cleaning off after a few minutes to a few hours is useful at the start of a new topical regiment); introducing longer contact time as tolerated
- Avoiding application just before bedtime may reduce the additive irritant occlusive effect of a pillow
- Using aqueous-based topicals, thereby avoiding irritants such as alcohol
- Explaining that visible improvement may take several weeks or months, and an initial flare of acne can occur
Moisturizers and Cleansers
An essential component of acne skin care management with
positive effects on adherence is the appropriate selection and
use of moisturizers and cleansers.2 Physicians can provide
information on key ingredients and suitable formulations to
assist patients in making informed decisions.
- Recommend aqueous moisturizers that are noncomedogenic, with minimal allergenic ingredients (e.g., fragrance and preservatives), and compatible with the chosen therapeutic regimen.
- Regular use of mild cleansers is an important aspect of optimal acne management. Routine cleansing is not only an essential part of basic hygiene, but it also removes dirt, sweat, bacteria, and exfoliated cells, preparing the skin to receive topical medications and improving drug absorption.
- Routine cleansing may enhance antimicrobial activity and decrease the chances of infection.
- Care must be taken to minimize any further disruption of the skin barrier during cleansing. The use of improper techniques and unsuitable cleansing agents can irritate or exacerbate existing lesions.
- The use of anionic detergents (i.e., soaps) can alter the pH of skin, resulting in increased skin sensitivity.
- Cleansers containing the surfactant sodium lauryl sulfate (SLS) can be irritating and further disrupt the skin barrier.5
- Avoid the use of soaps, foams, and mechanical cleansers (e.g., beads, brushes, and scrubs ), which can inadvertently damage intercellular lipids, leading to further impairment of the barrier function and cause dry skin.
- Cleansers that are suitable for acne-prone skin are generally based on mild synthetic surfactants that minimize barrier disturbances.
- Non-ionic surface-acting agents (e.g., silicone and polysorbate) are less likely to cause irritation and are formulated to the same pH as the skin (5.5).
- Silicone surfactants (e.g., dimethicone) are effective at eliminating surface debris without completely stripping away protective oils.
- Emollients contained in cleansers can minimize barrier damage by emulsifying dirt and oil for easy removal, while at the same time replacing lipids that are lost during the washing.6
- With the use of a mild cleanser, washing should be done twice daily.
Conclusion
Achieving adherence in acne patients often represents an
ongoing challenge. In order to realize therapeutic objectives,
pharmacologic initiatives must be accompanied by patient
education. Time devoted to counseling patients on avoiding
aggravating factors, medication use, and the importance
of maintaining proper skin care routines can contribute to
increased adherence. Finally, efforts aimed at early detection
and mitigation of poor treatment follow-through signs will
improve the outcome of therapeutic strategies.
References
- Tan JKL. Skin Therapy Lett Pharm 4(2):1-3 (2009 Jul-Aug).
- Dreno B, et al. Int J Dermatol 49(4):448-56 (2010 Apr).
- Vender RB. Skin Therapy Lett FP 4(2):1-3 (2008 May).
- Graham-Brown R, et al. Lecture Notes Dermatology 9th Edition (2007).
- Tsang M, et al. Br J Dermatol 163(5):954-8 (2010 Nov).
- Cork MJ. J Dermatolog Treat 8(Suppl 1):S7-13 (1997).